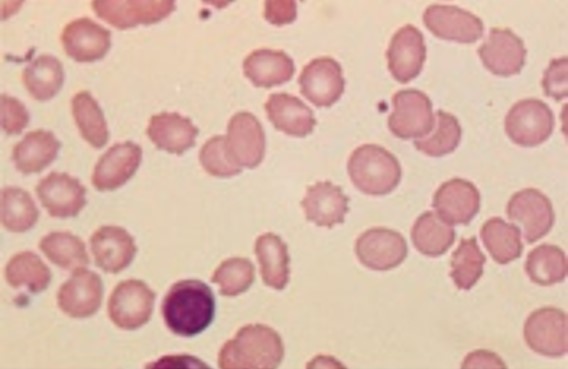

Medical Mystery of the Week
You are asked to make a diagnosis in this patient merely by looking at photos
of his skin, nails, and a Wright-Giemsa stain of his peripheral blood.
DIAGNOSIS: Uremia.
Symptoms of uremia may include fatigability, headache, anorexia, nausea and
vomiting, diarrhea, hiccups, restlessness, and depression. Depending upon its severity,
signs may include epistaxis, melena, uremic frost, half-and-half nails, Cheyne-Stokes
repirations, a fishy odor to one's breath (dimethylamine and trimethylamine), dehydration,
pericarditis, fasiculations, convulsions, delerium, coma, and asterixis. Some nephrologists
wait until patients with end stage renal disease develop signs of uremia before starting
hemodialysis.
A patient with a uremic frost which generally occurs at blood urea nitrogen levels ≥ 200mg/dL. Urea transporters and/or damage to cutaneous microvasculature and pilosebaceous units may account for its development (left panel). A half-and-half nail in which half of the nail is white and the other half is brown or red, one of the many cutaneous manifestations of uremia (middle panel). Other skin changes may be nonspecific (skin color changes, xerosis, pruritis) or specific (acquired perforating dermatosis, bullous dermatoses, metastatic calcifications, nephrogenic system fibrosis). Burr cells, formed in the presence of high blood urea nitrogen levels, as seen in a patient with uremia (right panel).
Sam Wilson West Parking Lot C...